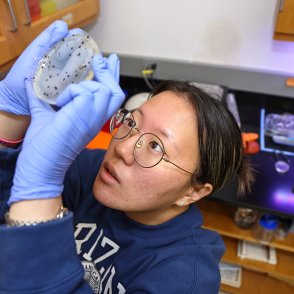

Zoology is the study of the diversity, classification, and behavior of animals as well as the molecular and physiological processes of animals. Zoologists explore how animals interact with other organisms and their environments and also how animals function at a genetic, cellular, molecular and physiological level.
About the Majors
Choosing to major in Zoology doesn't mean that you want to work at a zoo (unless that really is your goal). Graduates of OWU's highly-regarded Zoology program work as medical doctors and veterinarians, college professors, researchers with national agencies like the Department of Health and Human Services and the Centers for Disease Control, biologists with national parks and wildlife centers, writers and journalists, and, yes, even zoos.
Ohio Wesleyan's Zoology program gives you two major options, so you can create a program that fits your interests and career goals.
Zoology Bachelor of Science
A B.S. in Zoology is more suited for students preparing for medical school or graduate study in zoology. Completing this major will satisfy the minimum entrance requirements of almost all graduate programs in biology or zoology as well as meeting most of the prerequisites for medical, dental, and veterinary medicine schools. See the requirements and courses.
Zoology Bachelor of Arts
The B.A. in Zoology major is designed for students who are interested in the study of human beings and other animals, but perhaps do not want to pursue a professional career in medicine or zoology. Often, general zoology majors choose to double major in another discipline, further expanding their career options. See the requirements and courses.
OWU also offers a minor in Zoology.
Popular Second Majors
Students pursuing a B.S. in Zoology with a plan to pursue medical school also frequently complete the Pre-Medicine degree. Many students earning a B.A. also complete a major in Environmental Science. For students who choose to complete a second major, some of the other most popular majors have been: Botany, Spanish, Microbiology, and Philosophy.
Popular Minors for Zoology Students